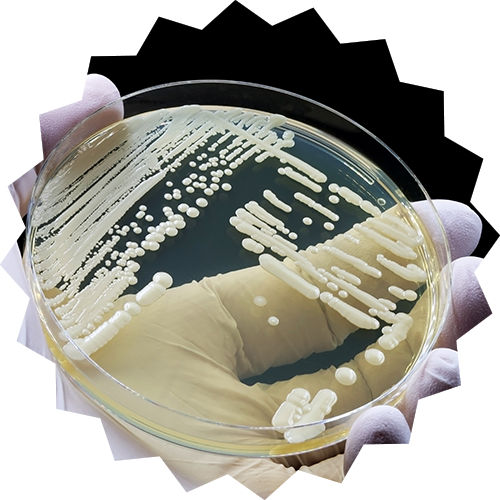
Yeast Infection

Skip the Walk-In. Get Relief in Minutes.
Book a quick, easy, and completely stress-free appointment with Sunshine Drugs Family of Pharmacies.
If you’re feeling sick, you shouldn’t have to sit in a crowded waiting room for hours just to be dismissed or have no solutions. We can fix that. You can book a quick, safe, private, and efficient appointment with knowledgeable pharmacists you trust. We assess multiple medical conditions known as “ minor ailments / illnesses ” that are short-term, require minimal treatment, and don’t require lab tests.
Speak with one of our caring pharmacists is easy. You can book online, call one of your nearest Sunshine Drugs locations, and even get free prescription deliveries after your assessments. Prefer in person? At any of our locations we accept walk-ins and will do an on-the-spot assessment. Our team will recommend, prescribe or suggest the right treatment plans, and make sure it’s safe with your current medications, all in one fast and easy visit. It’s simple, personal, and designed to help you feel better as quickly as possible.
Skipping the walk-in clinic line has never been easier and helping you and your loved ones to feel better is priceless. See a comprehensive list of minor ailments below and check if your minor ailment qualifies as a fast pharmacist assessment.
Comprehensive List of Minor Aliments Pharmacists in Ontario can Asses and Prescribe for Quickly

A urinary tract infection (UTI) is an infection in any part of the urinary system. The urinary system includes the kidneys, ureters, bladder and urethra. Infections that involve the lower urinary tract or "cystitis" of bacteria that causes the lining of the bladder and urethra to become red and irritated. An Ontario Pharmacist can treat and prescribe for lower bladder UTIs.
- Frequent urination, pain while urinating and difficulty holding in urine
- A strong urge to urinate that won't go away
- Urinating often and passing a small amount of urine
- Pain in the lower abdomen or pain in the centre of the pelvis and around the pubic bone
- Urine that looks bright pink or cola-coloured. (This could be a sign of blood in the urine.)
- Absence of vaginal discharge
- Cloudy or foul-smelling urine
Disclaimer: If you are experiencing fever, chills, flank/backpain, nausea/vomiting – these are a signal of a more serious infection and will need further testing from a doctor to rule out any potential complications. Pharmacists can only assess and prescribe for uncomplicated urinary tract infections (Cystitis UTIs) and must follow clinical guidelines when providing minor ailment services. A referral to a physician or a nurse practitioner might be considered if: pregnant, immunocompromised patients, relapse of UTI within 4 weeks of previous episode and individuals assigned male at birth.
If you don't have a valid Ontario health card (OHIP), professional fees might apply for assessments. In the event a prescription is written for this service, the cost of the medication is not included with the assessments. The cost may be covered by you or your drug insurance provider.
- Thick white vaginal shedding of fluids and cells, called discharge, with little to no odor, with a cottage cheese appearance
- Itching and irritation in the vagina and tissues at the vaginal opening called the vulva
- A burring feeling during intercourse or while urinating
- Rash, redness and swelling of the vulva
- Vaginal pain and soreness
Disclaimer: If you experience severe symptoms such as excessive redness, swelling and itching that leads to crack, tears or sores in the vagina, you have four or more yeast infections a year, you're pregnant, you have diabetes that isn't managed, weakened immune system because of medications or conditions like HIV infections make an appointment with your health care provider.
If you don't have a valid Ontario health card (OHIP), professional fees might apply for assessments. In the event a prescription is written for this service, the cost of the medication is not included with the assessments. The cost may be covered by you or your drug insurance provider.

Menstrual cramps (or dysmenorrhea) can become severe enough to interfere with your enjoyment of life. 50% of women in their childbearing years' experience painful menstrual cramps and that 15% of Canadian women cannot perform their normal daily activities for one to three days per month as a result.
- Pain, throbbing or cramps in the lower abdominal area that is mild to intense
- Pain in the lower back and starting before onset of a period
- Pain staring 1-3 days before your period, peaks 24 hours after the onset of your period and subsides in 2-3 days
- Pain lasting hours to days on end
- Dull continuous ache
- Other symptoms: Like nausea, loose stools, constipation, headaches, dizziness, mood swings, tender breasts, bloating, acne, anxiety, fatigue and food cravings.
Disclaimer: If you don't have a valid Ontario health card (OHIP), professional fees might apply for assessments. In the event a prescription is written for this service, the cost of the medication is not included with the assessments. The cost may be covered by you or your drug insurance provider.

Hemorrhoids, swollen and irritated veins, affect 50% of Canadians by the age of 50. Internal and external hemorrhoids can have the following symptoms:
- Itching, burning or swollen (with or without pain) around the anal/rectum area
- Bright red blood during / after bowel movement
- Swelling, inflammation, sitting on the toilet for long periods of time
- Constipation, straining, difficulty during a bowel movement
- Presence of a lump in the anal / rectum area
Disclaimer: Seek emergency care if you have large amounts of rectal bleeding, lightheadedness, dizziness or faintness. If you have changes in bowel habits, your stools change in color or consistency book an appointment with your health care professional. Rectal bleeding can happen with other diseases, including colorectal cancer and anal cancer.
If you don't have a valid Ontario health card (OHIP), professional fees might apply for assessments. In the event a prescription is written for this service, the cost of the medication is not included with the assessments. The cost may be covered by you or your drug insurance provider.

Hay fever / allergic rhinitis refers to allergic irritation to tree pollen (common in early spring), grass pollen (early spring and summer), ragweed pollen (common in fall), dust mites and cockroach droppings, molds, spores from indoor and outdoor fungi and molds, and animal dander that can contribute to year-round allergies
- Runny, stuffy/congested nose, trouble breathing through your nose
- Watery, itchy, red eyes, tearing up, swollen and red skin around eyes, bruised-appearing skin under eyes known as allergic shiners
- Sneezing, dry coughing
- Itchy nose, roof of mouth or throat
- Flu/Cold like Symptom's that last more than 7 continuous days
- Mucus that runs down the back of the throat, called postnasal drip
- Extreme tiredness and fatigued, often due to poor sleep
Disclaimer: Seek a healthcare professional if you can get relief from your hay fever symptoms, allergy medications are not working, or if you have other conditions like polyps, asthma, or frequent sinus infections.
If you don't have a valid Ontario health card (OHIP), professional fees might apply for assessments. In the event a prescription is written for this service, the cost of the medication is not included with the assessments. The cost may be covered by you or your drug insurance provider.

Pink eye (conjunctivitis) is an irritation and inflammation of the transparent membrane that lines the eyelid and eyeball, caused by allergies, viruses, or bacteria. Pink eye can be highly contagious, getting an early diagnosis and taking precautions can help limit its spread. If you wear contacts refrain from wearing as soon as pink eye symptoms have been identified.
- Redness, itching, a gritty sand like feeling, in one or both eyes
- Difficulty opening eyes, creamy yellow pus like discharge, crust forming overnight
- Tearing up, appearance of sticky or burning sensation
- Sensitivity to light, called photophobia
Disclaimer: See your eye doctor or care physician if you are experiencing sever eye pain, a persistent feeling of something being stuck in your eye, blurred vision, and light sensitivity – seek urgent care if you experience these symptoms. If symptoms do not clear up in 12-14 hours after receiving treatment see your eye healthcare professional to make sure you don't have a more serious eye infection due to contact lens use.
If you don't have a valid Ontario health card (OHIP), professional fees might apply for assessments. In the event a prescription is written for this service, the cost of the medication is not included with the assessments. The cost may be covered by you or your drug insurance provider.

Many people experience acid reflux now and then. However, when acid reflux happens repeatedly over time, it can cause acid flow back up into the esophagus and causes heartburn known as GERD. People likely to experience symptoms include those overweight or obese, smoke cigarettes, eat fatty foods, are older than 65, have high levels of stress in their life. One in four pregnant women experience heartburn every day! GERD can easily be managed with proper medicines.
- Burping/stomach acid rise from the stomach into the mouth
- Burning sensation in the chest, stomach, or rising to the neck after eating or while laying down
- Backwash of food or sour liquid in the throat
- Trouble swallowing (dysphagia), a sensation of a lump in the throat
- Trouble getting a good night's sleep because of heart burn
- Pain in the middle of the upper stomach area
- Nausea, ongoing cough
- New or worsening asthma
Disclaimer: Seek medical attention right away if you have chest pain. Especially if you have shortness of breath, jaw pain or arm pain. These may be symptoms of a heart attack.
If you don't have a valid Ontario health card (OHIP), professional fees might apply for assessments. In the event a prescription is written for this service, the cost of the medication is not included with the assessments. The cost may be covered by you or your drug insurance provider.

Strains commonly occur in the lower back and in the muscles at the back of the thigh (hamstrings). The difference between a strain and a sprain is that a strain involves an injury to a muscle and a sprain injures the bands of tissue that connects two bones together. RICE Rest, Ice, Compression and Elevation are initial remedies to heal. We can help guide you to items to help your recovery to happen effectively and quickly.
- Pain, swelling or tenderness (light to medium)
- Redness or bruising
- Limited motion and muscle weakness
- Muscle Spasms
- Injury is associated with overworking or muscle / joint injury pain
Disclaimer: If you don't have a valid Ontario health card (OHIP), professional fees might apply for assessments. In the event a prescription is written for this service, the cost of the medication is not included with the assessments. The cost may be covered by you or your drug insurance provider.

Morning sickness is feeling like throwing up or vomiting, and/or consistent nausea. Symptoms occur during pregnancy. Despite its name, morning sickness can strike at any time of the day or night.
- Nausea or vomiting at any time of the day due to pregnancy – especially during the first three months
- Certain smells, odors or eating certain foods causing you nausea/vomiting.
- Not able to keep food or drink down for more than 12 hours.
Disclaimer: If you have severe symptoms (six hours of consistent nausea and more than five episodes of vomiting or retching per day) or are experiencing weight loss or dehydration (e.g., infrequent/no urination, dark urine or only a little urine that is dark in colour), you can't keep liquids down, you feel dizzy/faint when you stand up, or your heart races, you should see your doctor as soon as possible.
If you don't have a valid Ontario health card (OHIP), professional fees might apply for assessments. In the event a prescription is written for this service, the cost of the medication is not included with the assessments. The cost may be covered by you or your drug insurance provider.

Irritant diaper rashes can be caused by moisture, sensitivities or friction/rubbing from tight or small diapers, yeast infections, food allergies, antibiotics or skin sensitivities, and/or harsh chemicals. When there is no yeast infection involved, it often only affects the surfaces of the skin (not the skin folds).
- Patches of inflamed, red, tender skin, around the diaper area – buttocks, thighs and/or genitals.
- Itchy tender skin with bright red patches, wrinkly-looking skin in the diaper area (common with yeast infections) or from chafing or rubbing.
- Painful sores in the diaper area that are inflamed for more than 3 days.
- Child is showing more than normal fussiness from pain, crying while urinating, during diaper changes and /or during defecating.
- Discomfort from diapers while sitting, sleeping or changes in normal sleep patterns.
Disclaimer: If the diaper rash hasn't improved after a few days of home treatment, you child has a fever, a rash that bleeds, itches or oozes, talk with. The rash may have another underling medical cause your doctor or other health care professional can assess with further testing.
If you or your child doesn't have a valid Ontario health card (OHIP), professional fees might apply for the assessments. In the event a prescription is written for this service, the cost of the medication is not included in the assessments. The cost may be covered by you or your drug insurance provider.

Acne is a skin condition that occurs when your hair follicles become plugged with oil and dead skin cells. It causes whiteheads, blackheads or pimples. Acne symptoms can range from mild, moderate, or severe. Mild and moderate acne is associated with pimples, blackheads, whiteheads, and oily skin.
- Whiteheads (closed pugged pores) and blackheads (open plugged pores)
- Small red, tender bumps (papules)
- Pimples (pustules), which are papules with pus at their tips
- Large, solid, painful lumps under the skin (nodules)
- Painful, pus filled, lumps under the skin (cystic lesions)
- Less than 30 total bumps/pimples and not all are inflamed (red in appearance)
- Areas of concern on face, forehead, neck, chest, upper back, shoulders, and upper arms.
Disclaimer: Severe acne is described as acne that has progressed to several large cysts or nodules that are firm and tender beneath the skin's surface. Severe acne can lead to scarring and should be treated by a skin specialist.
If you don't have a valid Ontario health card (OHIP), professional fees might apply for assessments. In the event a prescription is written for this service, the cost of the medication is not included with the assessments. The cost may be covered by you or your drug insurance provider.

Allergies to things like pollen or animal dander are more prone to eczema. Eczema is a condition that causes dry, itchy and inflamed skin. It's common in young children but can occur at any age. Atopic dermatitis is long lasting (chronic) and tends to flare sometimes. It's not contagious. Contact dermatitis happens when an irritant comes directly into contact with the skin. There are many irritants, such as poison ivy, detergents or chemicals that can cause contact dermatitis.
- An itchy rash on swollen skin that varies in colour
- Leathery patches that are darker than usual (hyperpigmented), typically on brown or black skin
- Dry, cracked, scaly skin, typically on white skin
- Bumps blisters, sometimes with oozing and crusting
- Swelling, burning or tenderness
- Raw, sensitive skin from scratching
Disclaimer: See your health care provider if: the rash is so itchy that you can't sleep or go about your day, the rash is severe or widespread, you're worried about how your rash looks, the rash doesn't get better within three weeks, the rash involves the eyes, mouth, face or genitals. Seek immediate care if you think your skin is infected and you have a fever along with yellow scabs, new streaks, pus oozing from blisters.
If you don't have a valid Ontario health card (OHIP), professional fees might apply for assessments. In the event a prescription is written for this service, the cost of the medication is not included with the assessments. The cost may be covered by you or your drug insurance provider.

Impetigo (i m-puh-TIE-go) is a highly contagious skin infection that affects mainly infants and children but can affect adults as well. Symptoms that first occur begins with red, itchy sores most often on the face and around the nose and mouth but can also affect areas like hands and feet. Sores burst in a couple days to a week and leak a fluid that turns into a honey-colored crust. Sores can spread to other areas of the body through touch, clothing and towels.
- Yellow discharge that dries to form a "golden" or "honey-coloured" crust
- Can affect face, mouth, feet, hands, arms or legs and is highly contagious
- Ages 2-5 years are most affected
- Broken skin, small cuts, scrapes on knees or elbows, rashes or insect bites can become infected with bacteria that causes impetigo
- Warm weather and humid weather conditions increase chances of infection
Disclaimer: Impetigo is rarely dangerous but in the case you feel it has not healed, see scarring, or other conditions seek immediate medical attention.
If you don't have a valid Ontario health card (OHIP), professional fees might apply for assessments. In the event a prescription is written for this service, the cost of the medication is not included with the assessments. The cost may be covered by you or your drug insurance provider.

Oral thrush (also called oral candidiasis) is an infection of fungus in the mouth that is caused by a yeast called candida that produces a thick, white coating on the tongue, the inside of the cheeks and lips, tonsils, gums or the back of the throat. Oral thrush usually isn't a big concern for healthy children and adults. But for people with lowered immunity, such as from cancer treatment or HIV/AIDS, thrush can be more serious.
- White or creamy-white spots / patches on the lips, inside the mouth, tongue and / or the roof of the mouth, gums and tonsils
- Cottage cheese-like, slightly raised patches
- Redness, burning or soreness that may be serious enough to cause a hard time eating or swallowing
- Patches can be scraped off, slight bleeding from being scratched/rubbed off
- Cracking and redness at the corners of your mouth
- Cottony feeling /dry mouth and or loss of taste
- Redness, irritation and pain under your dentures
Disclaimer: In some sever cases, if you or your child has trouble swallowing and feel pain or feel as if food is getting stuck in your throat, patches might have spread downward into your esophagus – the long, muscular tube stretching from the back of your mouth to your stomach. See your medical or dental professional to find out if you need to be checked for an underlying medical condition or another causes.
If you don't have a valid Ontario health card (OHIP), professional fees might apply for assessments. In the event a prescription is written for this service, the cost of the medication is not included with the assessments. The cost may be covered by you or your drug insurance provider.

Canker sores (also called aphthous ulcers) are small, shallow lesions that develop in the soft tissues in your mouth or at the base of your gums. Canker sores can be brought on by stress, changes in hormones, certain foods, medications or by injury to the inside of the mouth such as splayed bristles from an old toothbrush or if you wear dentures, that don't fit properly. Dentures that don't fit, may increase the risk of canker sores.
- Painful, small and shallow white-cream-coloured lesions with a raised red border that are round or oval
- Can be painful or irritated with acidic / sour foods
- Bumps appear in clusters of 1-100 inside the cheeks and lips, sides of tongue, roof and floor of mouth
- Less than 1 cm in diameter
Disclaimer: Consult your doctor if you are experiencing large canker sores (more than 1cm and not healing after 2-6 weeks) reoccurring ones that appear before old ones heal, frequent outbreaks, sores lasting two weeks or more, high fevers, and extreme difficulty when eating or drinking.
If you don't have a valid Ontario health card (OHIP), professional fees might apply for assessments. In the event a prescription is written for this service, the cost of the medication is not included with the assessments. The cost may be covered by you or your drug insurance provider.

Cold sores or fever blisters are a common viral infection that are tiny fluid filled blisters found in and around the lips. Cold sores heal in 2-3 weeks with scarring. Cold sores can spread and are highly contagious from close contact such as kissing or sharing food utensils and drinks. They're usually caused by herpes simplex virus type 1 (HSV-1), and less commonly herpes simplex virus type 2 (HSV-2). Both viruses can affect the mouth or genitals and can be spread by oral sex. The virus can spread even if you don't see the sores.
- Small fluid filled blisters that appear as a rash or small bump clusters around boarder of lips, nose, cheeks or sometimes inside the mouth.
- Redness or inflamed skin around rash with tender or slightly broken / soft skin that is painful to the touch
- The small fluid filled blisters may merge and then burst, and a painful blister with slight bleeding oozes a shallow sore and crusts over
Disclaimer: See your health care provider if the cold sores don't heal within two weeks, symptoms are severe, the cold sores often return, or you have a weak immune system.
If you don't have a valid Ontario health card (OHIP), professional fees might apply for assessments. In the event a prescription is written for this service, the cost of the medication is not included with the assessments. The cost may be covered by you or your drug insurance provider.

6-10 million species of insects are on Earth like bees, wasps, mosquitoes, spiders, bed bugs, black flies, horse flies, ant bites, flees, and mites that use their mouths to "bite" the skin. Insect bites that result into hives, redness, itching and swelling.
- Small bump or blister with pain, itching, redness or swelling
- Felling of a sharp burning and stinging pain
Disclaimer: Stings from bees, yellow jackets, wasps, hornets and fire ants might cause a severe allergic reaction (anaphylaxis). If you are experiencing trouble breathing, swelling of the face, lips, eyelids or throat, dizziness, fainting or unconsciousness, a weak rapid pulse, hives, nausea, vomiting or diarrhea – seek immediate medical attention. Call 911 or your local medical emergency number if a child is stung by a scorpion or if anyone is having a serious reaction that suggests anaphylaxis
If you don't have a valid Ontario health card (OHIP), professional fees might apply for assessments. In the event a prescription is written for this service, the cost of the medication is not included with the assessments. The cost may be covered by you or your drug insurance provider.

Pinworm infection is one of the most common worm infections worldwide. Pinworms, also known as threadworms, are parasites that can cause itching in the anal area. Pinworm infestation is most common in children between the ages of 5 and 14 years. If one person is infected, it is best to treat the entire family. Pinworm eggs are invisible to the eye and can be transmitted by hands, food and especially in large households. You can do a simple tape test at home or through a clinic or otherwise look for these symptoms:
- Detection of worms in stool or near anus
- Anal or vaginal itching, especially at night
- Restless sleep, trouble sleeping, insomnia, teeth grinding
- Occasinal stomach pain, upset stomach or vomiting
- Feeling irritable and having trouble concentrating
- Abdominal pain that comes and goes, bed wetting
Disclaimer: If you don't have a valid Ontario health card (OHIP), professional fees might apply for assessments. In the event a prescription is written for this service, the cost of the medication is not included with the assessments. The cost may be covered by you or your drug insurance provider.

Most tick bites are painless and cause only minor signs and symptoms, such as a change in skin color, swelling or a sore on the skin. Lyme disease and rocky mountain spotted fever is caused by bacteria that can be passed on to humans by a tick bite attached to a person's skin for at least 36 hours.
- Tick bite by black legged tick
- Red lump / bump with swelling, blistering, bruising, itching or other infections may develop
- Mild allergic reaction (hives, rash and light swelling at the bite site)
Disclaimer: Call 911 if you experience a severe headache, difficulty breathing, paralysis, or heart palpitations. Bring removed tick to your doctor for testing or have tick removed by your nearest clinic/ER.
If you don't have a valid Ontario health card (OHIP), professional fees might apply for assessments. In the event a prescription is written for this service, the cost of the medication is not included with the assessments. The cost may be covered by you or your drug insurance provider.
*A pharmacists advice and guidance does not replace your family doctor’s evaluations. A pharmacists knowledge is based on physical products, medications, ingredients and years of education in how chemicals work, heal, and regenerate or restore our bodies helping heal our bodies.

